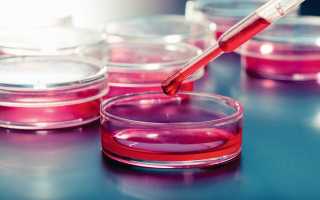
Норма Д-димера при беременности

Норма Д-димера при беременности (или другими словами – уровня кровяной свертываемости) – это один из самых важных показателей для будущей мамы, так как понижение или же, наоборот, повышение уровня свертываемости крови может стать причиной серьезных осложнений, среди которых самых тяжелым является угроза выкидыша.
Поэтому квалифицированные медицинские специалисты в течение всего срока беременности наблюдают за свертываемостью крови, а также за показателями и параметрами этого процесса.

Сдача анализа на Д-димер не обязательна, но в некоторых случая врач направляет женщину сдавать его минимум три раза за беременность
В виду того, что процесс тромбообразования – это многоступенчатый и очень сложный процесс, о нем нельзя судить по одному или нескольким показателям. Поэтому Д-димер беременности отображается согласно нескольким различным значениям коагулограммы, общего состояния женского организма, а также срока и триместра беременности.
Что же такое Д-димер?
Уровни Д-димера беременности – это суммарное количество белковых элементов в человеческой крови, которые появляются после полного распада фибрина. Если содержание белкового фрагмента повышено, то свертываемость крови увеличена, что может стать причиной риска появления тромбов во время беременности. Если же содержание белкового фрагмента понижено, это может стать причиной для появления кровотечений.
Появление Д-димера в организме – это результат целого комплекса реакций на различные повреждения сосудов и тканей:
- После того, как нарушается целостность тканей элемент фибриноген (это кровяной белок, который растворен в плазме) становится фибрином;
- Фибрин (или иначе – нерастворимый белок) отвечает за синтез и образование полимерных белых нитей, которые закрывают повреждения;
- В этих сетях и нитях копятся эритроциты и тромбоциты, из-за чего появляется сгусток, являющийся одним из важных препятствий для кровотечений; Клетки тканей делятся с большой активностью и скоростью, в результате чего происходит их скорейшее заживление;
- После того, как тромб не нужен, он начинает распадаться.
Важный момент: норма Д-димера беременности – это непостоянная величина, которая находится в прямой зависимости от возраста женщины, а также от общего показателя здоровья и триместра беременности.
Мнение врача:
Врачи отмечают, что уровень Д-димера, как показатель системы свертывания крови, может быть повышенным у беременных женщин. Это связано с физиологическими изменениями в организме во время беременности. Однако, важно учитывать индивидуальные особенности каждой беременной женщины при оценке уровня Д-димера. Повышенный уровень этого показателя может быть признаком тромбоэмболических осложнений, поэтому врачам необходимо тщательно оценивать симптомы и историю каждой беременной, чтобы исключить возможные осложнения. В случае выявления повышенного уровня Д-димера, врачи могут назначить дополнительные обследования и меры предосторожности для поддержания здоровья матери и ребенка.

Как проводится процедура анализа Д-димера
Если необходимо определить концентрацию, уровень и норму Д-димера беременности, необходимо взять кровь из вены. Следует отметить, что на проведение процедуры рекомендуется приходить рано утром, ведь необходимо принимать пищу более чем за восемь часов до проведения процедуры. Единственным исключением является вода.
Помимо этого, применение некоторых разновидностей медикаментозных препаратов может негативно или неправильно повлиять на результаты проводимых исследований. Именно поэтому необходимо предупредить врача и рассказать ему о каждом медикаментозном препарате, который был принят за последние 24 часа. Также рекомендуется отметить такую информацию в специализированном бланке.
Когда могут быть назначены исследования
Базовая коагулограмма проводится (рекомендуется к проведению) трижды за весь период беременности. Что же касается процедуры определения показателей и нормы Д-димера беременности, то они проводятся в таких случаях:
- если результаты и итоговые показатели предыдущего исследования выявили какие-либо нарушения или же отклонения в параметре свертываемости крови;
- если у женщины, ожидающей ребенка, есть какие-либо болезни, которое оказывают влияние на правильную работу свертывающей системы (это могут быть заболевания кровеносной системы, печени, а также варикоз и кровотечения);
- если у женщины была выявлена патология. Также если у женщины присутствует какой-либо из факторов риска беременности;
- если наступившая беременность является результатом не естественного, а именно искусственного оплодотворения;
- если у женщины есть заболевания, связанные с почками, сосудами, сердцем, а также различные гормональные и/или аутоимунные нарушения;
- если у женщины есть какие-либо интоксикации и/или вредные привычки.
Только врач решает, необходимо ли женщине контролировать уровень Д-димера
Норма уровней и показателей Д-димера беременности у женщин из групп и категорий, перечисленных выше, может как незначительно, так и очень сильно отличаться ото всех тех норм, которые являются общепринятыми и стандартизированными. Поэтому для того, чтобы правильно расшифровать результаты проведенных исследований в отдельных случаях, важно обращаться за консультацией к квалифицированному доктору.

Опыт других людей
Норма уровня д-димера в крови беременных женщин вызывает много вопросов и обсуждений среди специалистов и будущих мам. Д-димер – это белок, уровень которого может повышаться в случае тромбоза или воспаления. Во время беременности уровень д-димера обычно немного выше, что связано с изменениями в кровообращении. Однако значительное увеличение этого показателя может свидетельствовать о проблемах, таких как тромбоз или преэклампсия. Поэтому важно регулярно контролировать уровень д-димера во время беременности и обсуждать любые изменения с врачом для своевременного выявления и предотвращения осложнений.
Стоит ли следить за нормами и показателями Д-димера?
Вынашивание ребенка – это естественный и природно запрограммированный процесс, который сопровождается различными перестройками гормонов и организма. Любые изменения в женском теле, которые проходят во время беременности, являются физиологичными и заметными, то есть в случае необходимости их можно отследить с помощью различных лабораторных и/или инструментальных анализов. В некоторой степени при беременности меняются и основные моменты функционирования и работы кровообращения, а объем крови и ее циркуляции становится больше.
Все дело в том, что женский организм проводит своего рода подготовку к предстоящей кровопотере. Во время родов женщина теряет около 0,5 литра крови, поэтому крайне важно не допустить чрезмерной потери. Также крайне важно для организма женщины и ребенка минимизировать возможность образования кровотечений во время беременности. Все это можно контролировать при помощи анализов Д-димера.
Нормы для показателя
В действительности Д-димер беременности – это непостоянная величина, которая меняется пропорционально сроку. Также важно помнить: объемы циркулирующей крови в организме беременной женщины увеличиваются по ходу беременности на 1-1,5 литра, ведь необходимо снабжать достаточным количеством кислорода не только женщину, но и ребенка, который находится внутри.
Поэтому под конец родов, ближе к 9 месяцу, норма Д-димер беременности будет в несколько раз выше, нежели норма в начале беременности. Также следует помнить о том, что все изменения будут происходить не сразу, а постепенно.
Первый триместр.Для этого срока нормальными уровнями Д-димера – 500-700 нг/мл. Важно помнить о том, что данные цифры относительны, поэтому судить по ним о состоянии организма и здоровья будущей матери нельзя. Поэтому помимо этого показателя доктору также необходимо учитывать многие другие моменты и факторы
Есть вероятность, как серьезного понижения, так и серьезного повышения показателей и уровней свертываемости. Но лишь специалист в состоянии определить степень важности и существенности отклонения показателей от их нормального значения.
Второй триместр.Нормальный показатель – 900 нг/мл или ниже. Следует отметить, что этот показатель выше в два раза, чем тот же самый показатель, но до беременности. Тем не менее, существуют практические случаи, при которых значения показателей могут серьезно превысить данную границу, хотя состояние плода и матери при этом никак не ухудшаются.
Если показатели сильно увеличены для второго триместра, доктор может назначить будущей маме препараты-антикоагулянты. Очень часто будущую маму в случае повышенных показателей могут также направить в стационар для наблюдения.
Третий триместр.Во время третьего триместра показатель Д-димера может повыситься до 1500 нг/мл. Это нормальные показатели для третьего триместра, ведь именно в этом периоде организм женщины готовится к появлению ребенка.
Иногда показатели могут быть неизменными на протяжении двух триместров – это тоже один из вариантов нормы. Тем не менее, вне зависимости от показателей, в последний триместр уровень Д-димера должен сильно повыситься. Если же такого нет, то доктору необходимо провести диагностику и обследование.
Повышенный показатель
Повышенный показатель Д-димера беременности указывает на усиленное образование тромбов в женском организме. Помимо этого, массовое появление тромбов в организме – это один из характерных признаков для таких патологий и заболеваний в системе гемостаза, как:
- ДВС-синдром;
- тробоэмболия;
- наследственная тромбофиля.
Помимо всего прочего, такой показатель повышается при появлении или наличии различных заболеваний онкологического и/или инфекционного типа, а также при появлении или наличии процессов воспаления.

При повышении Д-димера возможно возникновение тромбоза
Появление высокого уровня Д-димера беременности вызывается различными ситуациями:
- патологии в развитии плода;
- отслоение всей или части плаценты раньше запланированного на это срока;
- многоплодная беременность;
- наличие каких-либо повреждений, а также их заживление;
- ревматоидные болезни, недуги и заболевания;
- инфекционные поражения;
- токсикоз тяжелой степени;
- предынсультное состояние;
- сахарный диабет вне зависимости от стадии;
- венозный тромбоз;
- нарушения в работе печени/почек или ССС;
- недавние операции.
Если во время беременности после нескольких анализов был определен большой скачек показателей Д-димера, это может говорить о том, что в теле женщины начали появляться кровяные сгустки. Как итог, это может быть ДВС-синдром или же тромбоэмболия.
Пониженный показатель
Очень редко можно наблюдать уменьшение уровня нормы Д-димера беременности. Иногда бывают незначительные уменьшения показателей, но они бывают настолько незначительными, что на них практически не обращают внимание. Однако, если есть понижение, которое заставляет обратить на себя внимание, женщину в срочном порядке отправляют на консультацию гематолога. Важно пройти соответствующее лечение, так как низкий показатель Д-димера во время беременности может говорить об обильном кровотечении в процесс родов и протекания беременности.
Д-димер и его нормы при ЭКО
При искусственном зачатии (т.е. экстракорпоральном оплодотворении) первым делом проводится качественная и продолжительная стимуляция фолликулов и поддержание цикличной лютеиновой фазы.

При ЭКО мониторинг Д-димера лишним не будет
Для того, чтобы этого добиться, будущей маме назначают специализированные препараты, оказывающие прямое влияние на параметры и уровни свертываемости крови. Д-димер в случае с ЭКО сильно повышен, поэтому нормы здесь, как при естественном оплодотворении, нет. Доктор при исследовании Д-димера в случае ЭКО ориентируется, в первую очередь, на динамику и отметки всех параметров, показателей и уровней коагулограммы.
Как расшифровываются результаты Д-димера
У анализа в итоговых результатах отмечается уровень концентрации показателя Д-димера. В различных лабораторных организациях может быть использована специализированная димер-эквивалентная единица, именуемая как DDU. Также может быть использована другая специализированная единица – фибриноген-эквивалентная, именуемая как FEU.
Возле числового показателя отмечается единица измерения, то есть, в данном случае, это нг/мл (или нанограмм на миллилитр). Могут быть и другие показатели, такие как миллиграмм на литр или микрограмм на литр (сокращенно мг/л и мкг/л). Соотношение единиц измерения проводится согласно формуле: 2 мг/л в формате FEU равны 1 мг/л в формате DDU.
Помимо всего прочего, у лабораторий есть и свои бланки для отображения результатов, но практически в каждом бланке есть такой параметр, как референсные значения. Этот параметр и определяет нормы Д-димера беременности.
Важно помнить: дешифрование полученных результатов не является источником полной, подробной информации о показателях свертываемости крови и всей кровеносной системы. Поэтому, чтобы понять степень и вероятность угрозы для матери или же для будущего ребенка, необходимо обратиться к квалифицированному медицинскому специалисту за подробной консультацией.
Вывод
Норма уровней для тех, у кого «не в положении» – 250 нг/мл. У беременных на начальных этапах показатель может быть таким же, но он должен расти пропорционально сроку беременности.
Влияние на уровень и идентификаторы Д-димера могут оказать болезни внутренних органов, а также инфекции или диабет.
Снижение идентификаторов и уровней Д-димера – это редко проявляющееся явление, которое представляет опасность для ребенка и будущей мамы.
Частые вопросы
Какой уровень Д-димера считается опасным?
Уровень D-димера 700 нг/мл и выше считается смертельно опасным. Снижение показателя свидетельствует о высоком риске кровотечений, поэтому пациенту требуется консультация гематолога и проведение дополнительного обследования.
Какой должен быть д димер в норме?
Международной средней нормой Д димер концентрации в крови для взрослого человека до 50 лет является показатель 250нг/мл, который говорит об отсутствии риска тромбозов. Границы нормы – в пределах от 500нг/л (0,55 мкг/мл) до 0. Верхняя граница нормы 500нг/л – точка принятия врачебного решения о состоянии пациента.
Как снизить уровень Д-димера в крови?
Как снизить Д-димер Проводятся дополнительные диагностические исследования. Среди них ультразвуковая допплерография или венография вен. Если причина высокого Д-димера в заболеваниях вен, назначаются антикоагулянты, препараты для разжижения крови для предотвращения дальнейшего образования тромбов.
Почему может быть повышен Д Димер?
Повышенный уровень D-димера обнаруживается при многочисленных состояниях, связанных с активацией коагуляции: синдром диссеминированного внутрисосудистого свёртывания крови, тромбоз глубоких вен, лёгочная тромбоэмболия, массивные повреждения тканей или хирургические операции, сердечная недостаточность, инфекции, …
Полезные советы
СОВЕТ №1
Обратитесь к вашему врачу или акушеру-гинекологу для оценки уровня D-димера в вашей крови во время беременности.
СОВЕТ №2
Избегайте самолечения и не пытайтесь интерпретировать результаты анализов самостоятельно. Обсудите любые вопросы и сомнения с медицинским специалистом.
СОВЕТ №3
Помните, что уровень D-димера может изменяться во время беременности, поэтому следуйте рекомендациям врача относительно необходимости повторных анализов.